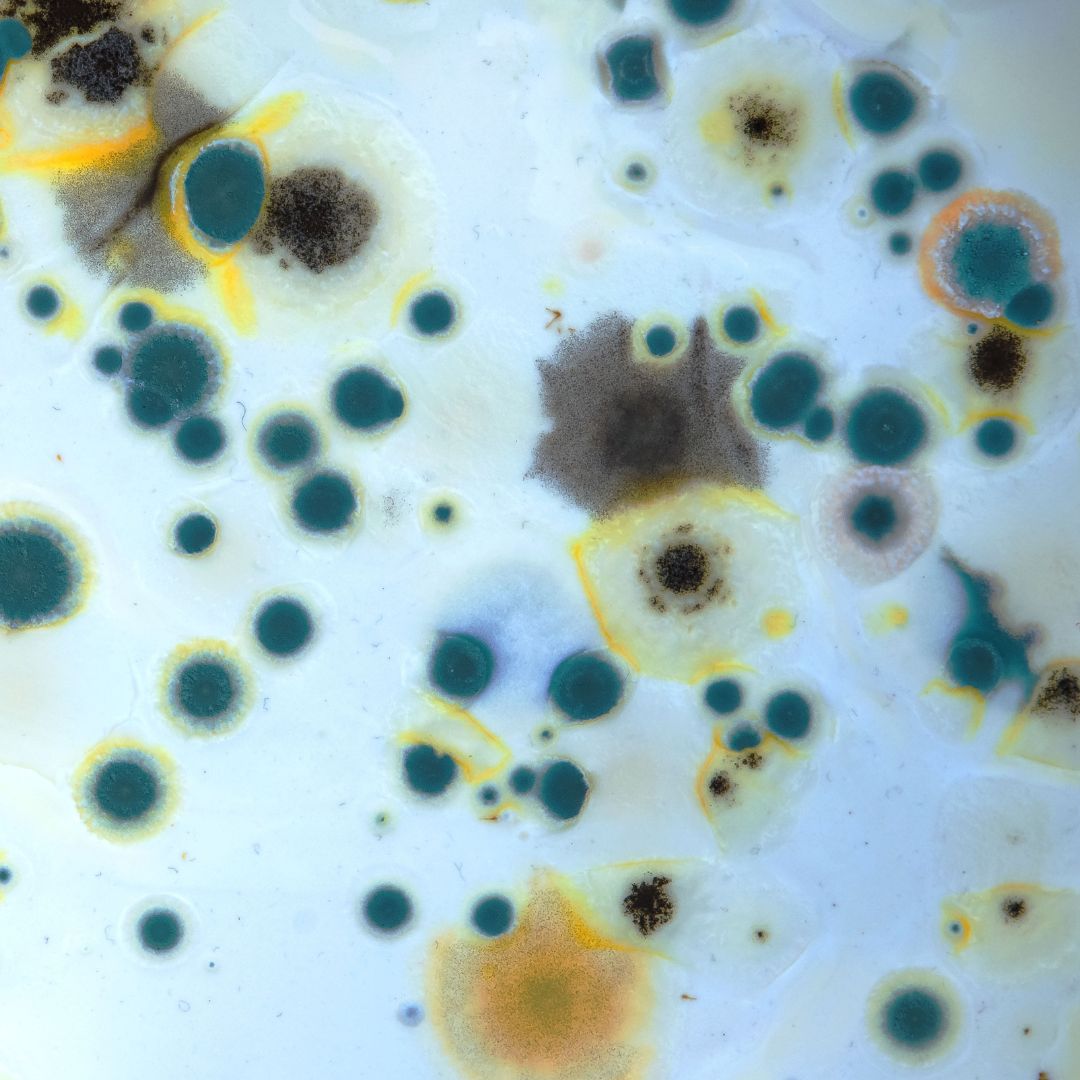

The Role of Proper Ventilation in Maintaining a Healthy Commercial Environment
Proper ventilation is a crucial factor in maintaining a healthy commercial environment. As commercial HVAC contractors in Jacksonville, FL, we understand the importance of having a well-functioning ventilation system in commercial spaces. In this blog, we will discuss the role of proper ventilation in maintaining a healthy commercial environment and how our team at Howard Services Air Conditioning can help.

The Importance of Proper Ventilation
Proper ventilation is essential for a commercial space to function efficiently. It helps to remove stale air and bring in fresh air, creating a comfortable and breathable environment. Without proper ventilation, the air can become stagnant and lead to a buildup of pollutants, which can negatively affect the health of employees and customers.
Regulating Temperature and Humidity
Proper ventilation is crucial in regulating a commercial space’s temperature and humidity levels. Inadequate ventilation can lead to high humidity levels, which can result in mold growth and discomfort for those inside the building. On the other hand, a well-ventilated space can help control the temperature and reduce humidity levels, creating a more comfortable and productive environment.

Improving Air Quality
Poor air quality can significantly impact the health of individuals in an enclosed space. Without proper ventilation, pollutants such as dust, allergens, and chemicals can accumulate and circulate in the air, leading to respiratory issues and other health concerns. A well-ventilated space helps to remove these pollutants and brings in fresh air, creating a healthier environment for everyone.

Reducing the Spread of Illnesses
In a commercial setting, where people are close to each other, the risk of spreading illnesses is high. Proper ventilation can help reduce disease spread by removing airborne viruses and bacteria. It also helps maintain a healthy humidity level, which can prevent the survival and growth of viruses and bacteria.
As a leading HVAC contractor in Jacksonville, FL, Howard Services Air Conditioning offers commercial HVAC services to help businesses ensure proper ventilation and a healthy indoor environment for their employees and customers. Contact us today to learn more about our services and how we can help improve your commercial space’s ventilation.
Get A FREE Consultation Today
Howard Services Air Conditioning
Business Hours
24/7 EMERGENCY
SERVICE AVAILABLE
